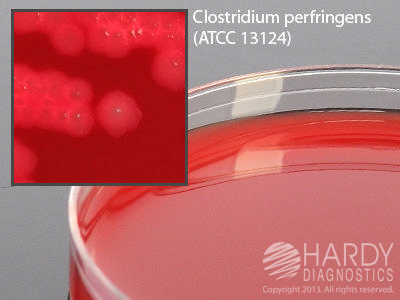

Schaedler Agar W/Sb H/K , Pack Of 10
$ 84.60
|
|
Details:
Schaedler Agar with Sheep Blood, H and K (Hemin and Vitamin K), 15x100mm plate^
Additional Information
| SKU | 23787636 |
|---|---|
| UOM | Pack of 10 |
| UNSPSC | 41106200 |
| Manufacturer Part Number | A98 |
| Product Dimensions | 16X5X7 Inches |
| Product Weight | 12 |
